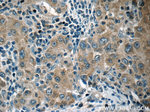
HSPH1 Antibody in Immunohistochemistry (Paraffin) (IHC (P))

Search
Proteintech
HSPH1 Polyclonal Antibody
{{$productOrderCtrl.translations['antibody.pdp.commerceCard.promotion.promotions']}}
{{$productOrderCtrl.translations['antibody.pdp.commerceCard.promotion.viewpromo']}}
{{$productOrderCtrl.translations['antibody.pdp.commerceCard.promotion.promocode']}}: {{promo.promoCode}} {{promo.promoTitle}} {{promo.promoDescription}}. {{$productOrderCtrl.translations['antibody.pdp.commerceCard.promotion.learnmore']}}
产品信息
13383-1-AP
种属反应
已发表种属
宿主/亚型
分类
类型
抗原
偶联物
形式
浓度
规格
纯化类型
保存液
内含物
保存条件
运输条件
产品详细信息
This antibody recognizes both HSP105alpha and HSP105beta isoforms. Western blot analysis using this antibody detected a major band around 100-110kD in Jurkat cells.
Immunogen sequence: MSSEADMEC LNQRPPENPD TDKNVQQDNS EAGTQPQVQT DAQQTSQSPP SPELTSEENK IPDADKANEK KVDQPPEAKK PKIKVVNVEL PIEANLVWQL GKDLLNMYIE TEGKMIMQDK LEKERNDAKN AVEEYVYEFR DKLCGPYEKF ICEQDHQNFL RLLTETEDWL YEEGEDQAKQ AYVDKLEELM KIGTPVKVRF QEAEERPKMF EELGQRLQHY AKIAADFRNK DEKYNHIDES EMKKVEKSVN EVMEWMNNVM NAQAKKSLDQ DPVVRAQEIK TKIKELNNTC EPVVTQPKPK IESPKLERTP NGPNIDKKEE DLEDKNNFGA EPPHQNGECY PNEKNSVNMD LD (508-858 aa encoded by BC037553)
靶标信息
HSPH1 prevents the aggregation of denatured proteins in cells under severe stress, on which the ATP levels decrease markedly. This protein inhibits HSPA8/HSC70 ATPase and chaperone activities.
仅用于科研。不用于诊断过程。未经明确授权不得转售。
生物信息学
蛋白别名: Antigen NY-CO-25; heat shock 105kDa/110kDa protein 1; Heat shock 110 kDa protein; Heat shock protein; Heat shock protein 105 kDa; Heat shock protein family H member 1; HSP; HSP105 alpha; HSP105 beta; KIAA0201; NY CO 25; unnamed protein product
基因别名: HSP105; HSP105A; HSP105B; HSP110; HSPH1; KIAA0201; NY-CO-25
UniProt ID: (Human) Q92598
Entrez Gene ID: (Human) 10808